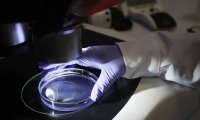
Американская разведка подготовила проект отчета о происхождении Covid-19

Британский аэропорт Хитроу призвал отменить ПЦР-тесты из-за увеличения числа пассажиров
В прошлом месяце через аэропорт Хитроу прошло больше людей, чем за все время пандемии, чему способствовало частичное открытие трансатлантического авиационного коридора.